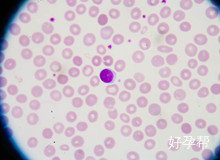
做试管婴儿有什么影响？试管婴儿真的值得做吗？

第 9 1 6 6 期
做试管婴儿有什么影响?试管婴儿真的值得做吗?
发布:2020-08-03 10:21:49
导语
对于大多数不孕不育夫妻来讲,他们在选择做试管婴儿的时候,可能也都会考虑到做试管婴儿有什么影响,其实从目前的情况来看,你可以发现试管婴儿这些手术并没有我们想象中的那么复杂,如果我们真的要选择实施试管婴儿这项手术的话,那么他们的影响并不是说特别强大
好孕百科 / 生男生女 / 做试管婴儿有什么影响?试管婴儿真的值得做吗?

导语
对于大多数不孕不育夫妻来讲,他们在选择做试管婴儿的时候,可能也都会考虑到做试管婴儿有什么影响,其实从目前的情况来看,你可以发现试管婴儿这些手术并没有我们想象中的那么复杂,如果我们真的要选择实施试管婴儿这项手术的话,那么他们的影响并不是说特别强大
做试管婴儿有什么影响?试管婴儿真的值得做吗?
对于大多数不孕不育夫妻来讲,他们在选择做试管婴儿的时候,可能也都会考虑到做试管婴儿有什么影响,其实从目前的情况来看,你可以发现试管婴儿这些手术并没有我们想象中的那么复杂,如果我们真的要选择实施试管婴儿这项手术的话,那么他们的影响并不是说特别强大,所以很多女性在选择做试管婴儿这项手术的时候,完全可以放平心态,只有这样才能给我们带来足够多的保障。

做试管婴儿有什么影响?
大多数不孕不育的夫妻基本上也都可能会想方设法地孕育出可爱的宝宝,可是他们尝试过更多的方法,似乎没有任何的结果,所以说他们可能会想到试管婴儿这条道路,当然很多女性朋友们可能对试管一开始的时候还是有一种担忧,他们觉得试管婴儿是一种大型的手术,对市管员有一些惧怕,但是看到那么多成功的人,可能他们也会感觉到特别羡慕,那么这样的一项手术的影响究竟大不大。
目前来看这种手术的影响其实并不是特别大,因为它是一个长期的诊疗过程,不过在每一个阶段都有相关的把控,在整个试管医疗手术实施的过程当中,在促排卵阶段取卵或者是整个试管婴儿胚胎移植的过程当中,可能和女性息息相关,这其中会涉及到一系列的检查,而且还有相关的用药,有人工取卵或者是其他的环节,每一个环节在操作的过程当中都是非常重要的,如果最终的环节操作不当的话,可能会对女性的身体产生一些影响。
试管婴儿真的值得做吗?
其实大多数的人在进行试管婴儿手术实施的过程当中,我们可能会想到各种不同的试管婴儿手术实施方法,在这里要提醒大家的就是试管婴儿这项手术相对来讲还是非常值得不孕不育的夫妻去尝试的,如果你的身体条件并不是特别好,或者是说在尝试这项手术之前,医生不建议大家去尝试,那么这种情况下建议大家考虑,但如果你的身体条件比较不错,可以尝试一下。


-
如何解开备孕疑惑,轻松好孕?
 备孕小夫妻,总是爱着急 我九月十号的预产期,闺女提前一周就发动了,在孕晚期的时候,总是希望闺女快点发动,没想到,自己在想和闺密去玩的三号这天早上五点左右就流了蛮多的分泌物,以为自己要生了,叫老公叫了他姐姐过来,我站在地板上,
我九月十号的预产期,闺女提前一周就发动了,在孕晚期的时候,总是希望闺女快点发动,没想到,自己在想和闺密去玩的三号这天早上五点左右就流了蛮多的分泌物,以为自己要生了,叫老公叫了他姐姐过来,我站在地板上, -
【我求你助】答疑会中奖名单公布啦!姐妹们快来围观吧~
 




















